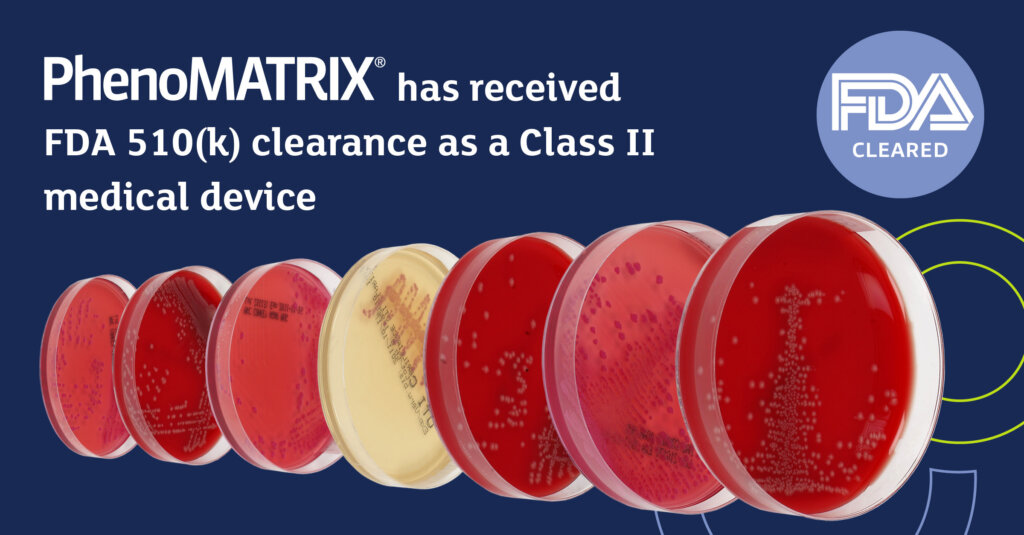

PhenoMATRIX® Receives FDA 510(k) Clearance: Advancing Digital Microbiology with Confidence
February 12, 2026
We are proud to announce that PhenoMATRIX® has received FDA 510(k) clearance (K251511) as a Class II medical device – a significant milestone in the evolution of digital microbiology.
This clearance confirms the intended use of PhenoMATRIX® as a Microbial Colony Image Assessment System and optional module of the WASPLab® automation platform, supporting laboratories in the automatic sorting of digital images of culture media plates using advanced image analysis and laboratory-defined expert rules.
For clinical microbiology laboratories navigating increasing workload demands, staffing pressures, and the need for standardized processes, this milestone represents more than regulatory achievement; it represents progress.
What FDA Clearance Means for Your Laboratory
PhenoMATRIX® is FDA 510(k) cleared for the automatic sorting of digital images of:
- Blood-based agar
- Chocolate agar
- MacConkey agar
- CHROMagar™ Orientation plates
The system performs semi-quantitative and qualitative image analysis to:
- Detect microbial growth
- Estimate colony counts
- Differentiate isolates based on phenotypic colony characteristics
Sorting decisions incorporate image analysis results together with clinical and demographic information from the LIS, according to expert rules defined and validated by the laboratory.
Importantly, all images are evaluated by trained laboratory personnel for final assessment and result definition. PhenoMATRIX® is designed to support microbiologists, not replace them, reinforcing the critical role of human expertise in clinical decision-making.
Driving Efficiency Without Compromising Oversight
Digital transformation in microbiology is no longer aspirational – it is essential. Laboratories face:
- Growing specimen volumes
- Increasing complexity of testing
- Workforce constraints
- Pressure to improve turnaround time
PhenoMATRIX® addresses these challenges by organizing culture plate images into laboratory-defined classification categories prior to technologist review.
By automatically sorting digital plate images, laboratories can:
Prioritize plates requiring further evaluation
By grouping images based on image analysis results and laboratory-defined criteria, technologists can quickly identify plates that require focused clinical assessment.
Streamline review of negative and insignificant cultures
Presumptive negative or low-significance culture plate images are organized into structured categories to support efficient review while maintaining trained personnel oversight.
Enhance consistency across technologists
By presenting sorted images according to predefined classification parameters, PhenoMATRIX® supports reproducible review processes
Support standardized interpretation criteria
The system applies consistent, laboratory-validated expert rules to image analysis results, helping ensure alignment with institutional protocols across all reviewed plates.
Standardization Through Intelligent Rules
At the heart of PhenoMATRIX® is its ability to apply patient data and laboratory-defined expert rules to sort the digital images for technologists to analyse results.
This means laboratories maintain control over how images are classified, ensuring alignment with validated protocols and institutional standards. By combining AI-driven image analysis with configurable expert rules and LIS-linked clinical context, PhenoMATRIX® supports reproducibility and workflow consistency across teams and shifts.
The result is not simply automation – it is intelligent standardization.
A Milestone for Digital Microbiology
FDA 510(k) clearance affirms the substantial equivalence of PhenoMATRIX® within the regulatory framework governing automated microbial colony image assessment systems. For laboratories considering digital transformation, this clearance provides additional confidence in the system’s intended use and clinical workflow role.
PhenoMATRIX® builds on Copan’s long-standing leadership in full laboratory automation, integrating seamlessly within the WASPLab® ecosystem to deliver a cohesive, digitally driven microbiology workflow.
Looking Ahead
As laboratories continue to modernize operations, the role of digital image assessment and structured workflow optimization will only grow in importance.
PhenoMATRIX® represents a step forward, bringing together advanced AI-driven image analysis, laboratory-defined rules, and LIS integration within a framework that preserves technologist oversight and clinical accountability.


